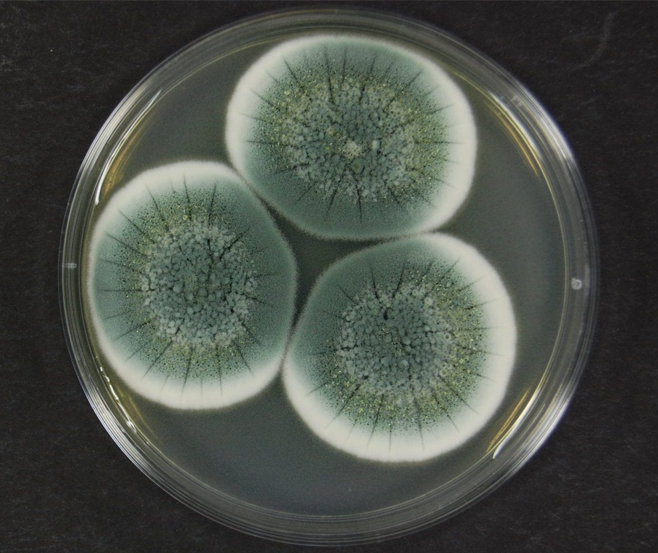

Sahasra - State of the Art R&D Centre
Sahasra Crop Science Private Limited (SCS) has its Core Research and Development Centre (S-CRDC) housed in a separateBuilding and located inside the R&D establishment factory premises with about 1000 Sq. ftResearch & Development Labs, about 873.3 Sq. ft R&D Pilot Plant and 5600 Sq. ft of R&DAgricultural Experimental Area. CRDC recognized by Department of Scientific and Industrial Research, Ministry of Science and Technology, Government of India. Our CRDC encompasses practices performed by businesses to evolve and launch new products as a foot step for process evolution in the Organic farming world, makes it possible for a firm to stay on top of its competition. Around the country, Sahasra crop science constantly stimulate creativity and ignite collaboration between CRDC and customers. As a part of our development, CRDC filed 7 patents. And formulations were launched in the Agri input marketglobally.


Sahasra Technology Development (STD)
S-CRDC developed Proteino Lacto Gluconate based crop specific bio formulations and commercialized. Grapcal - Our innovative formulation is mainly formulated to reduce fruit crack and improve fruit texture and saccharinity. This product mainly rich in free amino acid Arginine which are derived from organic based sources. Grapbud- mainly formulated to reduce abnormal bud breaking and enhance inflorescence primordia. This product mainly rich in free amino acid glutamine and cystine which are derived from organic based sources. Rice Rich-The conventional culturing methods are included with chemical fertilizers. But these cultivation methods having long term impact on soil and human health. Hence, we developed an foliar bio stimulant organic based formulation to resolve the problems associated with nutrients and yield. And More Mango- formulated to controlflower drop,enhance the texture of the fruit.
Sahasra R&D team not only doing research work in agricultural segment but also in the Animal, Aqua & Food Technology Segments.
Sahasra Microbial Culture Collection (SMCC)
The main objectives of SMCC facility are to supply authentic microbial cultures and to provide related services to the scientists working in S-CRDC. It plays a key role in developing innovative microbial products. Presently SMCC have 4 sections, Actinomycetes, Bacteria, Fungi, Yeasts and collectively holding three thousand five hundred cultures. All cultures are identified based on 16S rDNA genome based and preserved by freeze-drying. The fungi are also preserved under mineral oil. Viability and some key characteristics of the organisms are periodically checked so that cultures continue to represent the original properties. These cultures will be screened for their Special properties like production of metabolites, degradation of specific compounds and enzymatic activities, Plant Growth Promoting Activity. In SMCC, we characterized potential microbial cultures and deposited to GenBank and further used for product formulations.

Organic Agri inputs
S-CRDC Team works with the innovative ideas to develop bio stimulants, growth promoters and bio pesticides. As a part of development, we will develop liquid and powder formulations after different stages of evaluation at our In house. After In vitro screening, we will identify the best combinations at field levels. S-CRDC will be coming up with a plant growth regulator, effective biofertilizers, Soil surfactants and bio pesticides.
Sahasra- Core Research and Development Centre (S-CRDC)
Sahasra Crop Science Private Limited (SCS) has its Core Research and Development Centre (S-CRDC) housed in a separateBuilding and located inside the R&D establishment factory premises with about 1000 Sq. ftResearch & Development Labs, about 873.3 Sq. ft R&D Pilot Plant and 5600 Sq. ft of R&DAgricultural Experimental Area. CRDC recognized by Department of Scientific and Industrial Research, Ministry of Science and Technology, Government of India. Our CRDC encompasses practices performed by businesses to evolve and launch new products as a foot step for process evolution in the Organic farming world, makes it possible for a firm to stay on top of its competition. Around the country, Sahasra crop science constantly stimulate creativity and ignite collaboration between CRDC and customers. As a part of our development, CRDC filed 7 patents. And formulations were launched in the Agri input marketglobally.
Four Key Pillars

-
01
Science
-
02
Innovation
-
03
Collaboration
-
04
Growth
Product evaluation and activities at R&D
 Identification of Active Microbial Ingredients.
Identification of Active Microbial Ingredients. Physico-Chemical Analysis of microbial metabolites and formulations.
Physico-Chemical Analysis of microbial metabolites and formulations. Process parameters optimization and Analytical Analysis
Process parameters optimization and Analytical Analysis Technology Development and transfer to pilot scale.
Technology Development and transfer to pilot scale. Enhancement and evaluation of existing and developed products and validation in own fields.
Enhancement and evaluation of existing and developed products and validation in own fields. Patent filing and publication of scientific out put at Research and Development Centre.
Patent filing and publication of scientific out put at Research and Development Centre. Support to Registration & Export department of the company
Support to Registration & Export department of the company
Get in touch
Please leave the query you wish to have addressed below. We will contact you soon.